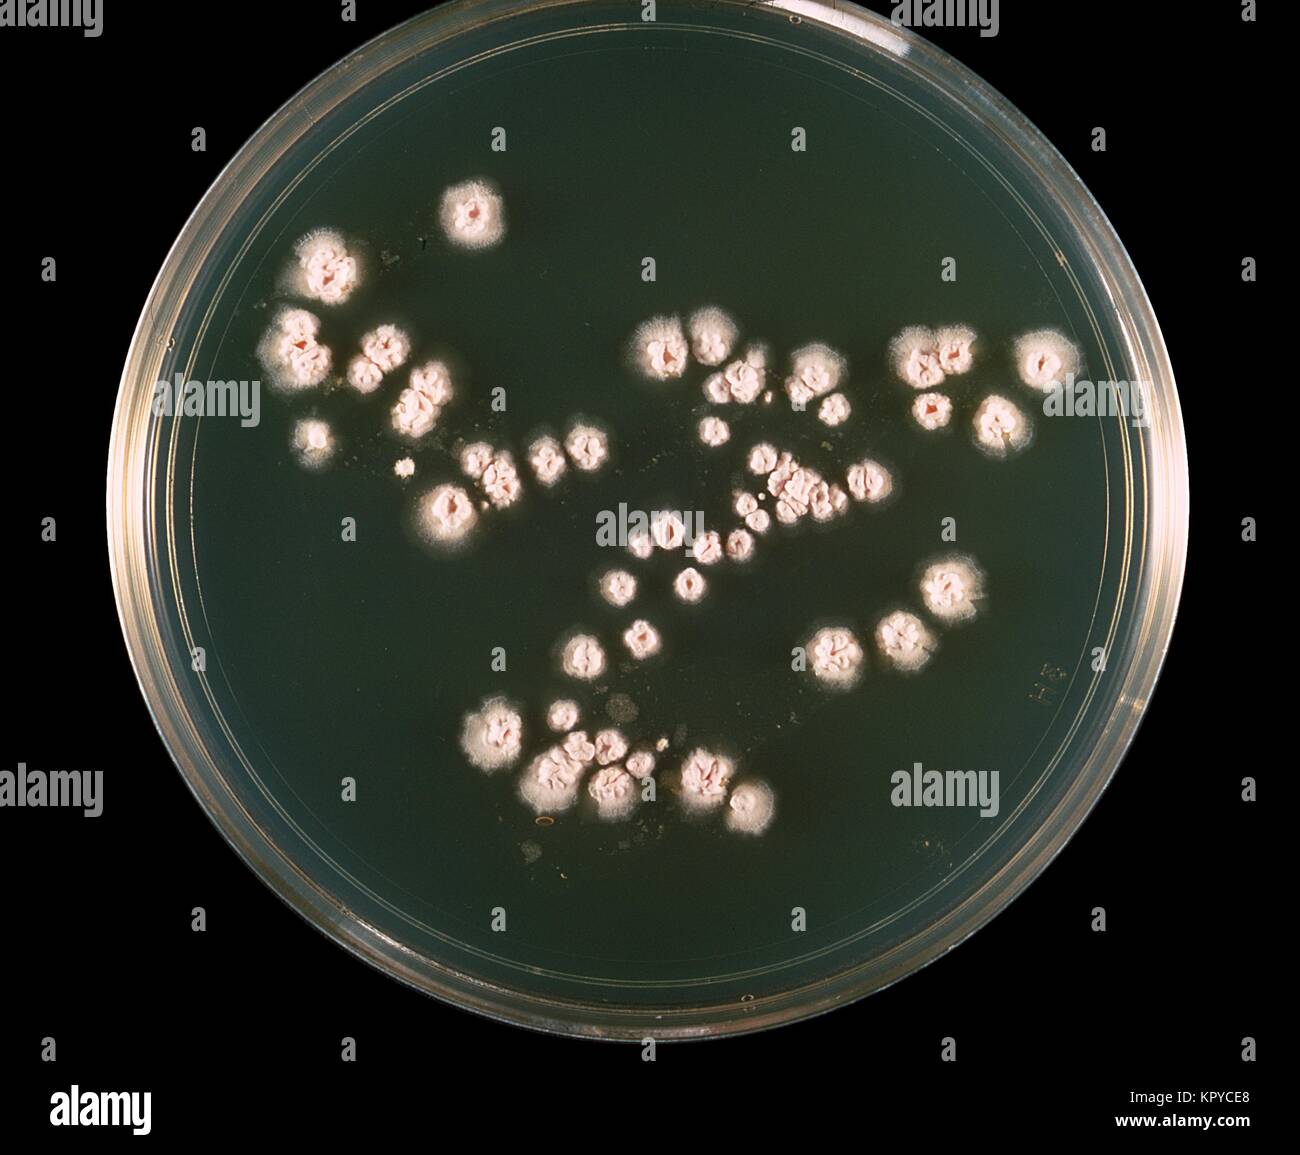
Il s'agit d'une culture de la plaque de la bactérie Nocardia asteroides cultivées sur milieu gélosé 7H10{} à 37 degrés C. Le complexe Nocardia astéroïdes bactérienne est une grave menace pour les sujets immunodéprimés, en particulier ceux avec les greffes, la maladie pulmonaire, et le SIDA, 1969. N. astéroïdes provoque au moins 50  % des infections invasives de Nocardiosis. Image courtoisie CDC/Dr. William Kaplan. Banque D'Images

Culture d'organes Photos Stock & Des Images
(13,708)Filtres rapides :
Culture d'organes Photos Stock & Des Images

RM2K2JYXN–Coupe de bois allemande du 16th siècle représentant des instruments de musique en cours de jeu. Les instruments inclus sont l'orgue et la flûte. Un chœur chante à côté.

RMJ30E1P–Le 'Berliner Drehorgellied-Ulk' de 1919 est un morceau de musique, probablement associé à la tradition allemande des moulins à orgue. La musique reflète la culture populaire de Berlin du début du XXe siècle.

RMPAC0HH–Musique à bouche. Culture : l'autrichienne. Dimensions : H. : 19 cm (7-1/2 in.) ; Diam. : 10,8 cm (4-1/4 in.). Bouilloire : P. Peckmann. Date : ca. 1835. Cet instrument, connu seulement par ce spécimen, a la forme d'un racket de la période baroque et a été apparemment conçu comme un 'nouveau racket historiciste.' Il parle avec la pression et d'aspiration, a deux par cinq doigts des boutons, et est à l'écoute comme un harmonica en D. La disposition des boutons, cependant, permet de jouer des accords, ce qui rend l'instrument particulièrement adapté pour l'accompagnement. Un autre concept a été de fournir une très grande chambre de résonance, sous la forme de cylindre en bois creux

RMHX96M8–Cette œuvre représente Paul Hofhaimer, compositeur de la Renaissance, assis sur un chariot avec un orgue positif. La peinture reflète la culture musicale de l’époque, ainsi que la représentation des musiciens dans des contextes historiques.

RMEB227N–Cathédrale Saint Michael architecture autel Belgique Brabant Flamand Bruxelles Bruxelles christianisme Église catholique culture d'organes de l'église

RF3BKWM4X–Orgue de la cathédrale Saint-Pierre de Poitiers, construit à partir de 1787 par François-Henri Clicquot. La construction de la cathédrale a commencé en 1166 sur l'emplacement des anciens édifices religieux, à l'initiative d'Éléonore d'Aquitaine et Henri II Plantagenêt, alors reine et roi d'Angleterre et ducs de Normandie et d'Aquitaine. Ils étaient d'importants mécènes des arts et de la culture de leur époque et ont fait don, entre autres, du célèbre vitrail représentant la Crucifixion dans l'abside. Rue Emile Faguet, Poitiers, Nouvelle-Aquitaine, France

RM2BF3HKX–L'orgue et la voix une fois de plus sous nos fenêtres. Deux hommes et leur hurdy-gurdy. Les deux hommes sont debout, regardant le spectateur. Un homme chante, tandis que l'autre grind l'organe.

RFJ5AXE2–Signal de conviction dieu signe l'œil de l'oiseau de la culture noire bw d'organes profonds jetblack basané

RFPFW6Y2–Rotterdam, Pays-Bas - le 7 juillet 2018 : les poupées sur un orgue de rue traditionnels hollandais nommé Rosalinda

RM2AXRWD1–Charles-Marie Widor (1844 – 1937) était un organiste, compositeur et professeur français, plus remarquable pour ses dix symphonies d'organes.

RM2WTXRF4–Détail de l'orgue historique, détruit et reconstruit après le tremblement de terre de 2009, dans la basilique de Santa Maria di Collemaggio. L'Aquila, Abruzzes, Italie

RM2YJN1ME–Vue intérieure en regardant vers l'orgue de Fredrikskyrkan (église Fredericks) sur Stortorget à Karlskrona, Blekinge, Suède.

RF2NT4NXM–Un orgue à canon (également appelé orgue à roulette ou orgue à manivelle) est un instrument de musique mécanique français (Orgue de Barbarie) composé de soufflets A.

RMKTMNYW–Le *BELG ORGL MUS* fait référence à une pièce musicale ou à une organisation en Belgique. Il peut être lié à la musique d'orgue belge ou à un ensemble interprétant des œuvres classiques, reflétant la culture musicale belge.

RMPB0FNG–Orgue à tuyaux. Culture : L'Américain. Dimensions : 16 ft. 1 in. × 9 ft. 3 in. × 9 ft. (490,2 × 281,9 × 274,3 cm). Bouilloire : Thomas Appleton (Américain, 1785-1872). Date : 1830. Cet orgue est le plus ancien et le meilleur produit existant du célèbre artisan Boston Thomas Appleton (1785-1872). Construit en 1830, probablement pour l'église de Hartford (Connecticut), il a été réinstallé par Emmons Howard en 1883 au Sacré-Cœur de l'Église Plains, New York, où il a été découvert et non utilisés en 1980. négligé L'organe de la conception et de l'acajou tonale conservateur Renaissance grecque cas refléter le modèle britannique de la fin du xviiie

RMHYEYTJ–Tableau de l'artiste géorgien Niko Pirosmani, représentant une scène de fête avec un broyeur d'orgue. Il met en lumière la culture populaire de la Géorgie à travers le style naïf de Pirosmani, qui reflète les traditions, les gens et la vie quotidienne de la société géorgienne.

RMEB227K–Cathédrale Saint Michael architecture autel Belgique Brabant Flamand Bruxelles Bruxelles christianisme Église catholique culture d'organes de l'église

RFJ5AXE5–Signal de conviction dieu signe l'œil de l'oiseau de la culture noire bw d'organes profonds jetblack basané

RMKPYBBD–C'est une plaque de culture Nocardia asteroides, souche 7H10, cultivées à 37{}degrés C. Le complexe de bactéries Nocardia astéroïdes est une grave menace pour les sujets immunodéprimés, en particulier ceux avec les greffes, la maladie pulmonaire, et le SIDA, 1969. N. astéroïdes provoque au moins 50 % des infections invasives Nocardiosis. Image courtoisie CDC/Dr. William Kaplan.

RM3BDJT7W–Allemagne - 29 juillet 2020 : vue intérieure de l'historique Dom de Trèves ou cathédrale de Trèves avec orgue à pipe
![Défilé des joueurs de tonneaux sur le Kurfuertsamm de Berlin le 07.07.2018. 170 participants de douze nations participent au 39ème Festival international des organes de barrel. [traduction automatique] Banque D'Images Défilé des joueurs de tonneaux sur le Kurfuertsamm de Berlin le 07.07.2018. 170 participants de douze nations participent au 39ème Festival international des organes de barrel. [traduction automatique] Banque D'Images](https://c8.alamy.com/compfr/2b75f6k/defile-des-joueurs-de-tonneaux-sur-le-kurfuertsamm-de-berlin-le-07-07-2018-170-participants-de-douze-nations-participent-au-39eme-festival-international-des-organes-de-barrel-traduction-automatique-2b75f6k.jpg)
RM2B75F6K–Défilé des joueurs de tonneaux sur le Kurfuertsamm de Berlin le 07.07.2018. 170 participants de douze nations participent au 39ème Festival international des organes de barrel. [traduction automatique]

RM3A3XJWJ–Orgue sur la galerie ouest, photographie intérieure de la Frauenkirche, ou cathédrale notre-Dame, à Munich, Bavière, Allemagne, pour usage éditorial seulement.

RF2DBKWTF–Orgue à pipe et sculpture en bois de la Vierge Marie in L'église de la ville de Gadebusch dans le nord de l'Allemagne

RMKE9741–Cette photographie vintage capture un moulin d'orgue jouant « la sérénade du moulin d'orgue », une mélodie populaire de l'époque, mettant en valeur la culture du divertissement de rue.

RMPAAEDC–Orgue à tuyaux. Culture : L'Américain. Dimensions : H. 8 ft. 8 in. (264,2 cm) ; W. 58 in. (147.3 cm) Spécification : open diapason 8 ft. (243,8 cm) 61 tubes en métal ; arrêté basse diapason 8 ft. (243,8 cm)17 tuyaux en bois ; arrêté diapason treble 8 ft. (243,8 cm) 44 tuyaux : f-d2, bois d# 2-c4 metal cheminée flûte ; dulciana 8 ft. (243,8 cm) 44 tubes en métal ; contrebasse 4 ft. (121,9 cm)17 tuyaux métal ; principaux treble 4 ft. (121,9 cm) 44 tubes en métal. Bouilloire : Richard M. Ferris (Américain, 1818-1858). Date : ca. 1850. Cet orgue a une espèce de rose avec une corniche surmontée d'ornements sculptés.

RMHKC122–L'Hydraulis, précurseur de l'orgue moderne, est un instrument grec ancien alimenté en eau. Cette œuvre dépeint le développement précoce de la technologie musicale et son rôle dans la culture ancienne.

RMEB227H–Cathédrale Saint Michael architecture autel Belgique Brabant Flamand Bruxelles Bruxelles christianisme Église catholique culture d'organes de l'église

RMH53546–Aile d'organes ( Angel ) Giovanni Agostino da Lodi - peintre italien 1495 1525 15e siècle Italie Italien

RFJ5AXDY–Signal de conviction dieu signe l'œil de l'oiseau de la culture noire bw d'organes profonds jetblack basané
RMKPYCE8–Il s'agit d'une culture de la plaque de la bactérie Nocardia asteroides cultivées sur milieu gélosé 7H10{} à 37 degrés C. Le complexe Nocardia astéroïdes bactérienne est une grave menace pour les sujets immunodéprimés, en particulier ceux avec les greffes, la maladie pulmonaire, et le SIDA, 1969. N. astéroïdes provoque au moins 50 % des infections invasives de Nocardiosis. Image courtoisie CDC/Dr. William Kaplan.

RM2RY452A–Joueur d'orgue de baril, Forêt Noire, coutumes, folklore, crème anglaise, traditions, folk culture, peuple, homme, Allemagne
![Défilé des joueurs de tonneaux sur le Kurfuertsamm de Berlin le 07.07.2018. 170 participants de douze nations participent au 39ème Festival international des organes de barrel. [traduction automatique] Banque D'Images Défilé des joueurs de tonneaux sur le Kurfuertsamm de Berlin le 07.07.2018. 170 participants de douze nations participent au 39ème Festival international des organes de barrel. [traduction automatique] Banque D'Images](https://c8.alamy.com/compfr/2b75f7m/defile-des-joueurs-de-tonneaux-sur-le-kurfuertsamm-de-berlin-le-07-07-2018-170-participants-de-douze-nations-participent-au-39eme-festival-international-des-organes-de-barrel-traduction-automatique-2b75f7m.jpg)
RM2B75F7M–Défilé des joueurs de tonneaux sur le Kurfuertsamm de Berlin le 07.07.2018. 170 participants de douze nations participent au 39ème Festival international des organes de barrel. [traduction automatique]

RM2SYDBYH–Orgue de Johannes Klais dans le coffret baroque de Johann Friedrich Wender, photographie intérieure de la Severikirche à Erfurt, Thuringe, Allemagne.

RM2HM64EF–Une couverture de fin de 19th siècle American Puck Magazine avec une bande dessinée d'un singe tournant la manivelle sur un orgue étiqueté 'Home Sweet Home Rule' avec un pied. Il porte un chapeau avec une plume appelée 'Parnell', et tient un shillelagh étiqueté '80 membres' dans une main et dans l'autre une chaîne attachée à la ceinture d'un homme britannique étiqueté 'J. Bull' (John Bull), qui danse. Le bâtiment britannique du « Parlement » est en arrière-plan.

RMDTG2J5–Cette photographie montre une salle contenant des chaises et un orgue à pompe, reflétant le design intérieur et la culture musicale de l'Université de Miami à Oxford, Ohio. Il fait partie de la collection historique de l’université.

RMH583DH–Vénus avec l'orgue dvd 1550 Par Berthe Morisot ou Tiziano Vecellio1490 - 1576), peintre italien Titien 16e siècle école Vénitienne Venise Italie

RF2APW15K–L'église Bamboo Organe est décorée avec des lanternes de Noël pour les neuf jours de masses d'aube qui se termine le 24 décembre.

RF2H5BJ1J–Intérieur de l'église Saint Ambrogio à Cuneo.La capitale de la province de Cuneo, région du Piémont, Italie.L'orgue a été construit par les frères Lingiardi de P

RFJ5AXE0–Signal de conviction dieu signe l'œil de l'oiseau de la culture noire bw d'organes profonds jetblack basané

RF2P0R3BM–Grand orgue de Hallgrímskirkja, un chef-d’œuvre au sein de l’église emblématique d’Islande. Un hommage à la foi, à la musique et aux paysages époustouflants qui l’ont inspirée

RMKPYC82–Il s'agit d'une culture de la plaque de la bactérie Nocardia asteroides cultivées sur milieu gélosé 7H10{} à 37 degrés C. Le complexe Nocardia astéroïdes bactérienne est une grave menace pour les sujets immunodéprimés, en particulier ceux avec les greffes, la maladie pulmonaire, et le SIDA, 1969. N. astéroïdes provoque au moins 50 % des infections invasives de Nocardiosis. Image courtoisie CDC/Dr. William Kaplan.

RF3A92DAC–Colonnes de basalte, les soi-disant tuyaux d'orgue à Scheibenberg, Erzgebirge, Saxe, Allemagne, Europe
![Défilé des joueurs de tonneaux sur le Kurfuertsamm de Berlin le 07.07.2018. 170 participants de douze nations participent au 39ème Festival international des organes de barrel. [traduction automatique] Banque D'Images Défilé des joueurs de tonneaux sur le Kurfuertsamm de Berlin le 07.07.2018. 170 participants de douze nations participent au 39ème Festival international des organes de barrel. [traduction automatique] Banque D'Images](https://c8.alamy.com/compfr/2b75f73/defile-des-joueurs-de-tonneaux-sur-le-kurfuertsamm-de-berlin-le-07-07-2018-170-participants-de-douze-nations-participent-au-39eme-festival-international-des-organes-de-barrel-traduction-automatique-2b75f73.jpg)
RM2B75F73–Défilé des joueurs de tonneaux sur le Kurfuertsamm de Berlin le 07.07.2018. 170 participants de douze nations participent au 39ème Festival international des organes de barrel. [traduction automatique]

RM2YMD0RJ–Orgue avec armoiries de la famille ducale de Württemberg-Oels dans l'église Sophia de Pokoj/Bad Carlsruhe, Voïvodie d'Opole, Pologne.

RMHKCJW4–Cette peinture anglaise du XIXe siècle montre un gentleman assis à un orgue, reflétant probablement l'importance de la musique et de la culture à l'époque victorienne. La peinture à l’huile capture l’apparence formelle du sujet et l’instrument détaillé.

RM2H8HWK7–Orgue de pipe l'orgue de pipe, dont les portes ont été peintes par G. Benso en 1634/5.Cathédrale ou cathédrale métropolitaine de Saint-Laurent révolutionnaire gothique 1110 terminé 17th siècle.Gênes Italie Italien.

RFPFW6Y1–Rotterdam, Pays-Bas - le 7 juillet 2018 : orgue de rue traditionnels hollandais nommé Rosalinda en été en face des appartements

RFJF4NPH–La religion, de Dieu, de la culture, de l'œil, de l'orgue, bijoux, bijoux, cuir, illustration,

RF2P0R38R–Grand orgue de Hallgrímskirkja, un chef-d’œuvre au sein de l’église emblématique d’Islande. Un hommage à la foi, à la musique et aux paysages époustouflants qui l’ont inspirée

RMKPYCG1–Il s'agit d'une culture de la plaque de la bactérie Nocardia asteroides cultivées sur milieu gélosé 7H10{} à 37 degrés C. Le complexe Nocardia astéroïdes bactérienne est une grave menace pour les sujets immunodéprimés, en particulier ceux avec les greffes, la maladie pulmonaire, et le SIDA, 1969. N. astéroïdes provoque au moins 50 % des infections invasives de Nocardiosis. Image courtoisie CDC/Dr. William Kaplan.

RF3B76WGH–Orgue en bois dans une salle d'exposition avec plafond en bois et atmosphère historique, Musée du monastère, Calw Hirsau, Forêt Noire, Allemagne, Europe
![Défilé des joueurs de tonneaux sur le Kurfuertsamm de Berlin le 07.07.2018. 170 participants de douze nations participent au 39ème Festival international des organes de barrel. [traduction automatique] Banque D'Images Défilé des joueurs de tonneaux sur le Kurfuertsamm de Berlin le 07.07.2018. 170 participants de douze nations participent au 39ème Festival international des organes de barrel. [traduction automatique] Banque D'Images](https://c8.alamy.com/compfr/2b75f66/defile-des-joueurs-de-tonneaux-sur-le-kurfuertsamm-de-berlin-le-07-07-2018-170-participants-de-douze-nations-participent-au-39eme-festival-international-des-organes-de-barrel-traduction-automatique-2b75f66.jpg)
RM2B75F66–Défilé des joueurs de tonneaux sur le Kurfuertsamm de Berlin le 07.07.2018. 170 participants de douze nations participent au 39ème Festival international des organes de barrel. [traduction automatique]

RFCNXT0D–Johann Sebastian Bach à l'orgue lors d'une répétition de chorale, historique de la gravure, 1888














































